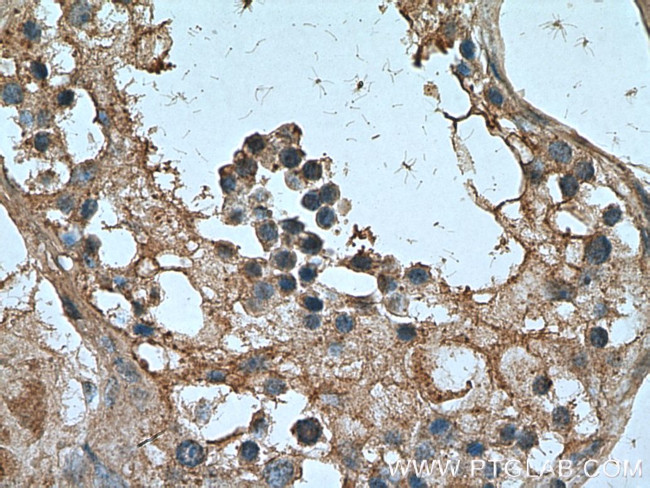
NANOS3 Antibody in Immunohistochemistry (Paraffin) (IHC (P))
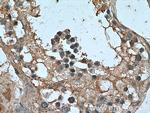
NANOS3 Antibody in Immunohistochemistry (Paraffin) (IHC (P))

Search
Proteintech
NANOS3 Polyclonal Antibody
{{$productOrderCtrl.translations['antibody.pdp.commerceCard.promotion.promotions']}}
{{$productOrderCtrl.translations['antibody.pdp.commerceCard.promotion.viewpromo']}}
{{$productOrderCtrl.translations['antibody.pdp.commerceCard.promotion.promocode']}}: {{promo.promoCode}} {{promo.promoTitle}} {{promo.promoDescription}}. {{$productOrderCtrl.translations['antibody.pdp.commerceCard.promotion.learnmore']}}
产品信息
21679-1-AP
种属反应
宿主/亚型
分类
类型
抗原
偶联物
形式
浓度
规格
纯化类型
保存液
内含物
保存条件
运输条件
产品详细信息
Immunogen sequence: MGTFDLWTD YLGLAHLVRA LSGKEGPETR LSPQPEPEPM LEPVSALEPM PAPESVPVPG PKDQKRSLES SPAPERLCSF CKHNGESRAI YQSHVLKDEA GRVLCPILRD YVCPQCGATR ERAHTRRFCP LTGQGYTSVY SHTTRNSAGK KLVRPDKAKT QDTGHRRGGG GGAGFRGAGK SEPSPSCSPS MST (1-192 aa encoded by BC101209)
靶标信息
Nanos is a zinc-finger containing, RNA-binding protein that has been implicated in germ cell development in both invertebrates and vertebrates. In Drosophila, Nanos represses apoptosis during development to ensure proper germ-line development. Unlike Nanos1 whose expression in mice is dispensable, the Nanos2 and Nanos3 proteins are required for germ cell development. Nanos2-null primordial germ cells (PGCs) die only in the male gonads and show no defects in females, while Nanos3-null PGCs are lost during the migration stage regardless of sex. Nanos2 and Nanos3 have distinct expression patterns during embryo development, suggesting that these two proteins do not have redundant functions. However, expression of Nanos2 can at least partially replace Nanos3 function in a Nanos3-null background. Nanos3 expression can not rescue Nanos2-null defects.
仅用于科研。不用于诊断过程。未经明确授权不得转售。
生物信息学
蛋白别名: Nanos homolog 3; NOS-3
基因别名: NANOS1L; NANOS3; NOS3; ZC2HC12C
UniProt ID: (Human) P60323, (Mouse) P60324
Entrez Gene ID: (Human) 342977, (Mouse) 244551, (Rat) 288909